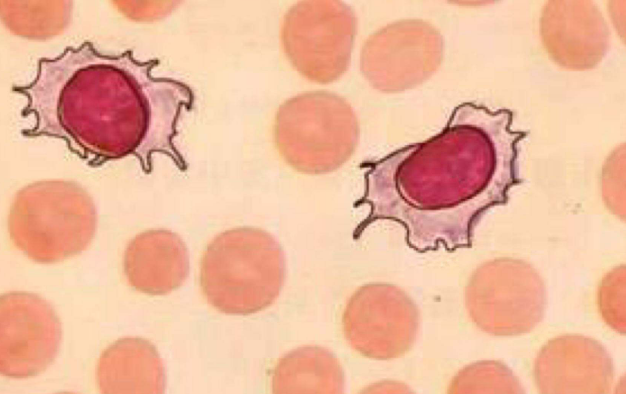

【资讯导读】威托克是一种处方药。可治疗的疾病包括成人慢性淋巴细胞性白血病或无17p缺失的小淋巴细胞性淋巴瘤,且已治疗至少一次。与阿扎胞苷、地西他滨或低剂量阿糖胞苷联合使用,用于治
威托克是一种处方药。可治疗的疾病包括成人慢性淋巴细胞性白血病或无17p缺失的小淋巴细胞性淋巴瘤,且已治疗至少一次。与阿扎胞苷、地西他滨或低剂量阿糖胞苷联合使用,用于治疗新出现的成人急性髓系白血病(AML): 75岁或以上,或患有其他疾病,妨碍使用标准化疗。你怎么看待那威托克?
根据威托克的说明或医生的建议服用。每天带维克多去一次,大约在同一时间吃一顿饭和喝水。整个吞下药片。不要咀嚼、压碎或打碎药片。如果您错过了一剂威托克,并且服用时间不到8小时,请尽快服用。如果您错过了一剂维托克,并且已经超过8小时,请跳过错过的剂量,在正常时间服用下一剂。不要改变威托克的剂量或停止服用,除非你的医疗保健提供者告诉你这样做。
首次服用威托克时,患者需要在医院或诊所服用威托克以监测TLS。如果威托克服用CLL或SLL,您的剂量将在5周内每周缓慢增加,直到达到最大剂量。如果您服用威托克治疗急性髓细胞白血病,开始威托克的治疗剂量。你的剂量会慢慢增加到最大日剂量。当增加到最大剂量时,请遵循医生的意见。
威托克药品详细信息请进入:https://www.inmedf.com/zhongliu/bxb/20201624.html